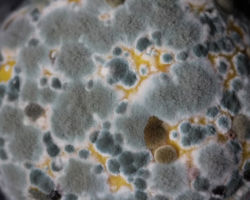

Se anche voi avete in casa un frigorifero di diversi anni, per gli standard moderni è già vecchio in un certo senso. Tuttavia, congela ancora bene, è spazioso e resiste bene alle interruzioni di corrente impreviste.
Pertanto, non c’è motivo di sostituirlo con un pezzo nuovo. Di tanto in tanto, però, si presenta un problema che non piace a nessuno: le muffe. Anche se compaiono raramente, rendono il problema ancora più frustrante.
Provate un rimedio che vi libererà da questo fastidioso problema. Inoltre, scoprite le cause della muffa nel vostro frigorifero.
unsplash
MOTIVI
Umidità all’interno del frigorifero
Pertanto, solo gli alimenti completamente raffreddati e la verdura e la frutta secca dovrebbero essere messi in frigorifero.
Pulizia rara del frigorifero
Pezzi di cibo, latte versato, briciole e altri avanzi dimenticati sullo scaffale diventano il terreno perfetto per la formazione di muffe.
Cibo scadente
Se nel frigorifero ci sono zuppe acide, verdure e frutta in decomposizione, salumi appiccicosi, la muffa comparirà presto nel vostro frigorifero.
MEZZI PER AIUTARVI A ELIMINARE FUNGHI E MUFFE DAL FRIGORIFERO
Aceto da tavola
Inumidire una spugna e trattare le aree con la muffa. Lavare e asciugare tutte le superfici interessate.
Perossido di idrogeno
Trattare le aree con muffa con una soluzione concentrata. Lasciare agire per qualche minuto e poi lavare.
Amonia
Diluire con acqua in rapporto 1:5. Inumidire un panno con la soluzione e pulire le aree segnate dalla muffa.
Sapone per il lavaggio
Grattugiatela e mescolatela con acqua. Strofinare le aree con la muffa con acqua e sapone.
Soda
Diluire 1 pl di soda in 1 litro di acqua calda. Trattare le aree interessate con la soluzione. Se c’è molta muffa, preparare una soluzione più concentrata.
Anche se la muffa è più comune nei frigoriferi vecchi che in quelli nuovi, questo non significa che i nuovi apparecchi non debbano essere curati.
E come vi comportate con la muffa nel vostro frigorifero? Condividi la tua esperienza!